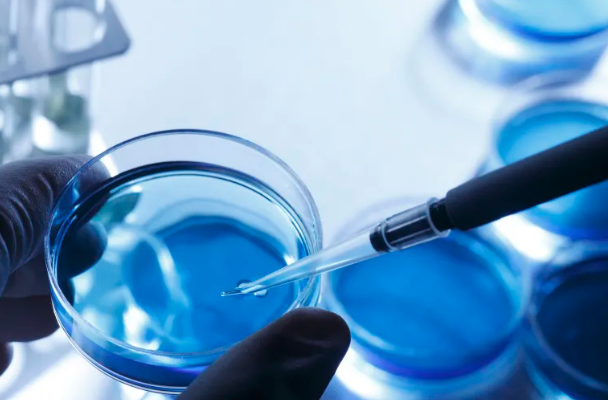
image.png

多能干細(xì)胞的作用以及應(yīng)用范圍有哪些
2024-09-02 15:03:09 來(lái)源: 小編 咨詢醫(yī)生
多能干細(xì)胞(Pluripotent Stem Cells)是指能夠分化為多種細(xì)胞類型的干細(xì)胞,具有自我更新和多向分化的能力。它們?cè)谠偕t(yī)學(xué)、疾病模型構(gòu)建、藥物篩選和基因治療等方面展現(xiàn)出廣泛的應(yīng)用前景。
多能干細(xì)胞的作用
1.自我更新能力
多能干細(xì)胞具備在體外持續(xù)增殖的能力,通過(guò)細(xì)胞分裂不斷生成子細(xì)胞,從背景環(huán)境中“應(yīng)對(duì)”不同的生理狀態(tài)。這一特性使得科研人員能夠在實(shí)驗(yàn)室中大量擴(kuò)增干細(xì)胞,為深入研究和臨床應(yīng)用提供了豐富細(xì)胞資源。
2.多向分化能力
多能干細(xì)胞能夠在特定培養(yǎng)條件下,分化為胚內(nèi)外胚層的細(xì)胞,如神經(jīng)細(xì)胞、心肌細(xì)胞、肝細(xì)胞等。這一能力使得它們?cè)谠偕t(yī)學(xué)中擁有重要的應(yīng)用潛力。例如,利用多能干細(xì)胞修復(fù)損傷的組織或器官,為治療一些難治性疾?。ㄈ缗两鹕?、心臟病)提供新思路。
3.疾病模型構(gòu)建
多能干細(xì)胞能夠形成體外組織模型,這為科學(xué)家們研究各種人類疾病的機(jī)制提供了良好的平臺(tái)。例如,利用患者來(lái)源的多能干細(xì)胞構(gòu)建神經(jīng)退行性疾病模型,可以解析相關(guān)的病理過(guò)程,并幫助開(kāi)發(fā)新藥物。
4.基因治療
多能干細(xì)胞在基因治療中的潛在應(yīng)用極為重要。通過(guò)基因編輯技術(shù)(如CRISPRCas9),研究人員可以對(duì)多能干細(xì)胞進(jìn)行基因修復(fù)或修改,再將其分化成目標(biāo)細(xì)胞用于恢復(fù)體內(nèi)缺失的功能。
多能干細(xì)胞的應(yīng)用范圍
1.再生醫(yī)學(xué)
多能干細(xì)胞在再生醫(yī)學(xué)中的應(yīng)用包括器官再生、組織工程等。通過(guò)有效的分化策略,將多能干細(xì)胞轉(zhuǎn)化為需要的細(xì)胞類型,可以在臨床上為器官功能障礙患者提供治療。
2.藥物篩選與毒性測(cè)試
利用多能干細(xì)胞來(lái)源的具體細(xì)胞類型,科學(xué)家們能在藥物開(kāi)發(fā)過(guò)程中進(jìn)行高通量篩選,評(píng)估藥物的療效和毒性,從而加速新藥的上市進(jìn)程。
3.移植治療
在移植領(lǐng)域,多能干細(xì)胞可以為器官缺損或功能障礙患者提供新的器官或組織。同時(shí),它們的應(yīng)用也延伸至個(gè)體化治療,通過(guò)患者自身細(xì)胞的回收和再登用降低排異反應(yīng)。
4.癌癥研究
多能干細(xì)胞在腫瘤研究中同樣扮演著重要角色。通過(guò)建立腫瘤干細(xì)胞模型,科學(xué)家們能夠研究腫瘤的生物學(xué)特性,評(píng)估治療反應(yīng)及其耐藥機(jī)制。
5.再生醫(yī)學(xué)的倫理問(wèn)題
盡管多能干細(xì)胞的應(yīng)用前景光明,但倫理問(wèn)題始終是其研究和應(yīng)用過(guò)程中的一大挑戰(zhàn)??蒲袡C(jī)構(gòu)需確保研究的合法性,確保不侵犯人類的倫理準(zhǔn)則。
多能干細(xì)胞作為現(xiàn)**物醫(yī)學(xué)的前沿領(lǐng)域,其獨(dú)特的性質(zhì)和廣闊的應(yīng)用范圍,無(wú)疑將為人類健康帶來(lái)新的希望。隨著研究的深入及技術(shù)的發(fā)展,我們期待在未來(lái)能夠?qū)崿F(xiàn)更多的臨床應(yīng)用。
文章來(lái)源:https://www.2008eshop.cn/ganxibao/37316.html?admin_id=1?
-
上一頁(yè): 打干細(xì)胞作用,注射干細(xì)胞的五大作用
-
下一頁(yè): 捐獻(xiàn)造血干細(xì)胞疼嗎有什么影響
- 2024-09-27貝拉國(guó)際醫(yī)療中心是正規(guī)醫(yī)院?jiǎn)?/a>
- 2024-09-15造血干細(xì)胞的基本特征,造血干細(xì)胞的三個(gè)特點(diǎn)
- 2024-07-24干細(xì)胞治療肝硬化,干細(xì)胞治療肝硬化效果怎么樣
- 2024-07-29干細(xì)胞的分化過(guò)程,干細(xì)胞的分化程度高嗎
- 2024-10-19打干細(xì)胞能治失眠嗎,失眠打干細(xì)胞的注意事項(xiàng)及費(fèi)用
- 2024-11-01干細(xì)胞有哪些有益作用?如何應(yīng)用于臨床治療?
- 2024-09-07干細(xì)胞療法要做多久,打一次干細(xì)胞能維持多久
- 2024-09-16干細(xì)胞療法上市藥物,中國(guó)批準(zhǔn)的干細(xì)胞藥物
- 2024-08-03胚胎干細(xì)胞抗衰老,胚胎干細(xì)胞抗衰的原理
- 2024-09-02上游干細(xì)胞存儲(chǔ)中游機(jī)構(gòu),細(xì)胞存儲(chǔ)公司排名前十
- 2024-08-30干細(xì)胞移植是骨髓移植嗎,附具體操作流程
- 2024-07-17干細(xì)胞療法治療腦梗有效果嗎,干細(xì)胞治療腦梗最新進(jìn)展
- 2024-09-02捐獻(xiàn)造血干細(xì)胞疼嗎有什么影響
- 2024-09-11干細(xì)胞提取過(guò)程,干細(xì)胞提取方法和設(shè)備
- 2024-09-03干細(xì)胞療法應(yīng)用前景,臨床治療哪些病癥
- 2024-09-28自體干細(xì)胞能存儲(chǔ)多久,存儲(chǔ)費(fèi)用多少錢
- 2024-09-04干細(xì)胞調(diào)節(jié)失眠效果好嗎,干細(xì)胞可以治療失眠嗎
- 2024-09-14國(guó)家干細(xì)胞存儲(chǔ)公司有哪些,內(nèi)附公司名單
